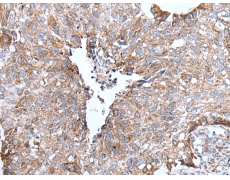
一抗

中文名稱: 兔抗UGGT1多克隆抗體
|
Background: |
UDP-glucose:glycoprotein glucosyltransferase (UGT) is a soluble protein of the endoplasmic reticulum (ER) that selectively reglucosylates unfolded glycoproteins, thus providing quality control for protein transport out of the ER. |
|
Applications: |
ELISA, WB, IHC |
|
Name of antibody: |
UGGT1 |
|
Immunogen: |
Synthetic peptide of human UGGT1 |
|
Full name: |
UDP-glucose glycoprotein glucosyltransferase 1 |
|
Synonyms: |
UGT1; HUGT1; UGCGL1 |
|
SwissProt: |
Q9NYU2 |
|
ELISA Recommended dilution: |
5000-10000 |
|
IHC positive control: |
Human colorectal cancer and human cervical cancer |
|
IHC Recommend dilution: |
25-100 |
|
WB Predicted band size: |
177 kDa |
|
WB Positive control: |
A172 cell lysate |
|
WB Recommended dilution: |
200-1000 |



 購物車
購物車 幫助
幫助
 021-54845833/15800441009
021-54845833/15800441009